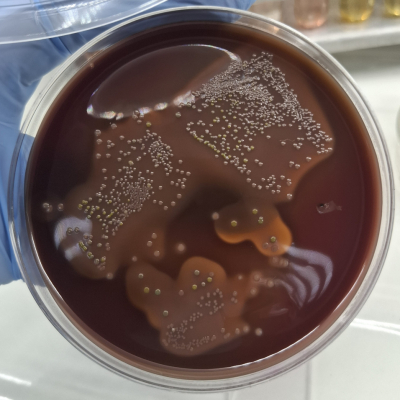
5

В отдел бактериологии, паразитологии и питательных сред Краснодарской испытательной лаборатории ФГБУ «ВНИИЗЖ» 18.02.2026 г. доставлен труп собаки породы Кане-корсо для патологоанатомического вскрытия, а впоследствии и бактериологического исследования, необходимых для установления причины внезапной гибели животного. При патологоанатомическом исследовании обнаружены: геморрагическое воспаление слизистой оболочки дна желудка, геморрагическое воспаление кишечника, гемоперикардит, пакреатит, застойная гиперемия печени, венозная гиперемия почек, геморрагические инфильтраты селезёнки, отёк легких. При бактериологическом исследовании материала обнаружен возбудитель инфекционной энтеротоксемии Clostridium perfringens, тип А.
Описанная выше патологоанатомическая картина характерна для острого отравления или тяжёлого инфекционного процесса (септического состояния). Ведущим механизмом является генерализованное повышение сосудистой проницаемости и ДВС-синдром.
ДВС-синдром (диссеминированное внутрисосудистое свертывание) — это тяжелое жизнеугрожающее нарушение свертываемости крови. Оно характеризуется образованием множества мелких тромбов в сосудах (блокировка кровотока), что приводит к истощению факторов свертывания и последующим массивным кровотечениям. Всегда является осложнением другого опасного заболевания. Специалистами исключено отравление солями тяжелых металлов.
Ключевые патологоанатомические признаки свидетельствуют о:
Инфекционная энтеротоксемия собак — острое токсико-инфекционное заболевание, вызываемое бактериями Clostridium perfringens (типы A, C, D), характеризующееся тяжелым геморрагическим энтеритом, сильной интоксикацией, обезвоживанием и высокой смертностью. Возбудитель выделяет токсины, поражающие кишечник. Лечение включает антибиотики, гипериммунную сыворотку и симптоматическую терапию.
Возбудитель: Анаэробные бактерии Clostridium perfringens (чаще типов C и A).
Симптомы:
Причины возникновения: неблагоприятные условия содержания, нарушение кормления, стресс, приводящие к размножению клостридий в кишечнике.
Диагностика: бактериологическое исследование с постановкой реакции нейтрализации на белых мышах или морских свинках.
Лечение:
Профилактика: соблюдение санитарных норм, качественное питание, ранняя диагностика.
Важно знать: энтеротоксемия часто протекает сверхостро, поэтому при появлении симптомов необходимо немедленно обратиться к ветеринарному врачу.